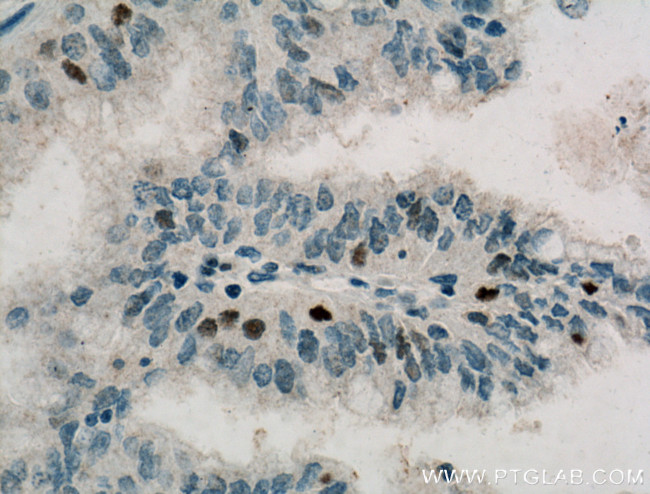
Cyclin D3 Antibody in Immunohistochemistry (Paraffin) (IHC (P))

Search
Proteintech
Cyclin D3 Monoclonal Antibody (1F2C6)
{{$productOrderCtrl.translations['antibody.pdp.commerceCard.promotion.promotions']}}
{{$productOrderCtrl.translations['antibody.pdp.commerceCard.promotion.viewpromo']}}
{{$productOrderCtrl.translations['antibody.pdp.commerceCard.promotion.promocode']}}: {{promo.promoCode}} {{promo.promoTitle}} {{promo.promoDescription}}. {{$productOrderCtrl.translations['antibody.pdp.commerceCard.promotion.learnmore']}}
产品信息
66357-1-IG
种属反应
宿主/亚型
分类
类型
克隆号
抗原
偶联物
形式
浓度
规格
纯化类型
保存液
内含物
保存条件
运输条件
产品详细信息
Immunogen sequence: MELLCCEGT RHAPRAGPDP RLLGDQRVLQ SLLRLEERYV PRASYFQCVQ REIKPHMRKM LAYWMLEVCE EQRCEEEVFP LAMNYLDRYL SCVPTRKAQL QLLGAVCMLL ASKLRETTPL TIEKLCIYTD HAVSPRQLRD WEVLVLGKLK WDLAAVIAHD FLAFILHRLS LPRDRQALVK KHAQTFLALC ATDYTFAMYP PSMIATGSIG AAVQGLGACS MSGDELTELL AGITGTEVDC LRACQEQIEA ALRESLREAS QTSSSPAPKA PRGSSSQGPS QTSTPTDVTA IHL (1-292 aa encoded by BC011616)
靶标信息
The protein encoded by this gene belongs to the highly conserved cyclin family, whose members are characterized by a dramatic periodicity in protein abundance through the cell cycle. Cyclins function as regulators of CDK kinases. Different cyclins exhibit distinct expression and degradation patterns which contribute to the temporal coordination of each mitotic event. This cyclin forms a complex with and functions as a regulatory subunit of CDK4 or CDK6, whose activity is required for cell cycle G1/S transition. This protein has been shown to interact with and be involved in the phosphorylation of tumor suppressor protein Rb. The CDK4 activity associated with this cyclin was reported to be necessary for cell cycle progression through G2 phase into mitosis after UV radiation. Several transcript variants encoding different isoforms have been found for this gene. Diseases associated with CCND3 include Retinoblastoma and Plasma Cell Leukemia.
仅用于科研。不用于诊断过程。未经明确授权不得转售。
篇参考文献 (0)
生物信息学
蛋白别名: CCND 3; CCND3; CGD3; CyclinD3; D3 type cyclin; D3-type cyclin; G1/S-specific cyclin-D3; OTTHUMP00000223415; RP5-973N23.3; unnamed protein product
基因别名: CCND3
UniProt ID: (Human) P30281
Entrez Gene ID: (Human) 896